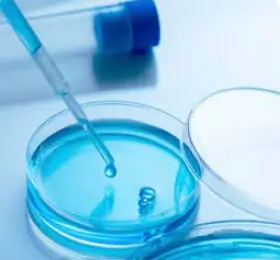
Osmometers for Industry and Research

The World of Osmometry
The Next Generation of OSMOMAT® FreezePoint® is HereAbout Osmometry
These properties include the Freezing point, Vapor pressure, Osmotic pressure, and Boiling point. The two measurement methods—freezing point and vapor pressure—are explained in detail below.
An osmometer is a device used in Hospitals, clinical laboratories and diagnostic centres and research industry for measuring the concentration of particles in a solution, known as the osmolar concentration. This quantity can be expressed as osmolality (in mmol/kg) or osmolarity (in mmol/L). Clinical laboratories typically measure osmolality, which is considered more precise as weight is temperature independent. In laboratory analysis, a dissolved substance is referred to as a solute, and the substance in which the solute is dissolved is referred to as a solvent. A solute dissolved into a solvent creates a solution.
The unit for osmolar concentration or osmolality is milliosmole (abbreviated mOsm or mOsmol). For nonelectrolytes, 1 mmol equals 1 mOsm, whereas for electrolytes, the number of particles in a solution depends on the electrolyte's dissociation. When a solute is dissolved into a solvent, 4 colligative properties of the solvent change.
FreezePoint® vs. Vapro®
The two most commonly used osmometers for this purpose are the Freezing Point Osmometer and the Vapor Pressure Osmometer. Although both measure osmolality, their readings can differ for the same sample, including for the same reference standard.
Note: The Vapro osmometer uses the SI unit "mmol/kg" for osmolality, while the FreezePoint osmometer uses the non-SI unit "mOsmol/kg." Both units are numerically identical in the context of osmolality but may differ in other contexts.
Vapor Pressure Measurement Method
Vapor Pressure Osmometry measures the dew point depression (e.g., decrease in the dew point temperature) of a solution using a thermocouple. The presence of dissolved particles predictably reduces the vapor pressure and hence the dew point temperature of the solvent. The dew point of the sample changes the temperature of the sensor and, according to the temperature, the voltage of the sensor changes (as it gains or loses water vapor depending on the relative humidity in the VPO solution cell).

Suited for a variety of applications, except for solutions containing volatile solutes, as these can alter the vapor pressure and lead to inaccurate measurements.

Vapor Pressure Principle:
- The sample solution is loaded onto a solute-free paper disk using a pipette and loaded into the measurement chamber which is then sealed.
- The temperature of the chamber and the solvent vapor inside are allowed to equilibrate.
- Thermo-electric cooling cools the thermocouple to below the dew point of the vapor.
- Solvent vapor condenses on the thermocouple. The latent heat of vaporization heats the thermocouple, and the temperature rises asymptotically towards the dew point temperature.
Freezing Point Measurement Method
During the measurement, the sample is first supercooled below its expected freezing point. The controlled injection of the ice crystal ensures a reproducible start to the freezing process. As crystallization occurs, the temperature rises until it reaches a stable plateau phase, which represents the actual freezing point of the sample. Since the presence of solute particles lowers the freezing point in a linear, predictable manner, the system can determine the osmolality with extreme accuracy. Our high-precision temperature sensor captures this point with a resolution of 0.001 °C, ensuring the highest level of diagnostic confidence.

Preparation: Place the measuring vessel onto the highprecision thermistor probe.

Controlled Cooling: The sample is lowered into the cooling chamber, where a microprocessor-controlled Peltier element coolsit to a sub-zero temperature.

Initiation: Once the sample is supercooled, a cooled triggering needle (cryst-needle) initiates the freezing process by injecting an ice crystal.

Crystallization: This triggered crystallization releases latent heat (thermal energy), causing the sample temperature to rise.

Freezing Point Principle:
- Super-cooling of the solution below freezing point. Due to the rapid cooling the sample does not freeze immediately.
- Crystallization is induced by injection of ice crystals and release of crystallization heat.
- During crystallization of the sample the heat of formation is released which increases the temperature of the solution until the freezing point is reached (plateau/maximum). The presence of solute particles predictably lowers the freezing point of the solvent.
- The plateau or slight slope of the temperature curve persists until complete crystallization, followed by a sharp drop inthe curve upon complete crystallization.
Factors Contributing to Discrepancies in Results
The factors contributing to discrepancies in results can be divided into two main groups: those related to the solutions themselves and those associated with the measurement devices. Solution-related factors include non-ideality of solutions and temperature dependence, while device-related factors encompass inherent limitations or shortcomings in the measuring methods.
Non-Ideality of Solutions
- FPO: More accurate for ideal, dilute solutions where solute-solvent interactions are predictable.
- VPO: Provides reliable results for solutions with specific properties, such as those where vapor pressure measurement is advantageous. This can be particularly useful in samples where freezing point measurement is impractical or less accurate.
-
Osmolality: Osmolality is a "constructed property," meaning it's not directly measurable but derived from the colligative properties of a solution. It quantifies the number of osmotically active particles present, making it an effective measure of solution concentration. Both the FPO and VPO measure changes in colligative properties, which are then utilized to compute osmolality. This process involves making assumptions and approximations based on ideal solution behavior.
Essentially, osmolality is determined by measuring alterations in the solvent's physical properties induced by the solute, rather than being directly measured. -
Impact: Complex and non-ideal solutions can lead to significant discrepancies between FPO and VPO readings due to differing sensitivities to solute behavior. The two devices measure different solution properties at different temperatures, resulting in possible discrepancies in osmolality measurements of the same sample between the two devices. Therefore, neither measurement is inherently more accurate, as both are based on different models, physical properties, and temperatures.
These shifts in osmolality measurements depend on the specific components of each sample and cannot be generalized.
These discrepancies can surface within comparative studies , , . While one osmometer type or the other may produce the most accurate results based on specific properties of a sample in question, much of the reference data is collected with FPOs, which can influence or bias what is accepted as accurate.
Temperature Dependence
Solution properties like osmolality and water activity, which hinge on solute-solvent interactions, are inherently temperature dependent. This dependence arises from the dynamic variations in interactions between solute and solvent molecules, as well as among solute particles, as temperature fluctuates.
- Solution properties like osmolality and water activity, which hinge on solute-solvent interactions, are inherently temperature dependent. This dependence arises from the dynamic variations in interactions between solute and solvent molecules, as well as among solute particles, as temperature fluctuates.
- FPO: The osmolality values of the NaCl standards (calibrators) are formulated based on a reference temperature of 0°C. This aligns with the FPO which uses 0°C as the reference point, as the measurement is based on freezing point depression. This alignment minimizes potential biases in the results.
- VPO: The osmolality values of the NaCl standards (calibrators) are formulated based on a reference temperature of 0°C. However, the VPO operates at room temperature (~25°C). Since osmolality is temperature dependent, using NaCl standards formulated for measurement at 0°C but measured at 25°C can introduce a bias. Despite this, it is common practice to use calibration standards formulated for 0°C when calibrating a VPO because standard reference tables are based on this temperature. As a result, VPOs inherently compensate for this temperature-dependent bias as part of the calibration process. This approach normalizes to 0°C but is only accurate for pure NaCl solutions. The temperature dependence may be different for other, particularly more complex, solutions.
-
Impact: The different measurement principles (FPO vs. VPO) and the corresponding sample temperatures can introduce bias due to temperature-induced changes. This bias is more pronounced at higher osmolality readings. For example, at lower concentrations, such as those below approximately 500 mmol/kg (which includes the physiological range), temperature-induced changes in vapor pressure are minimal, resulting in negligible bias between properly calibrated devices (e.g., osmometer types).
Conversely, at higher concentrations, typically starting from about 1000 mmol/kg (though sometimes as low as 500 mmol/kg for certain solutions), these changes are more significant, potentially causing noticeable discrepancies in results between different osmometer types for the same sample. Nevertheless, proper calibration of both FPO and VPO can minimize these discrepancies, ensuring reliable measurements across various osmolality ranges.
Applicability
The FreezePoint and Vapro osmometers can complement each other and may overlap in certain applications. They should be promoted particularly in scenarios where one is more suited than the other.
FreezePoint® Freezing Osmometer
FPO performs rapid measurements (60 s/sample), is simple to use, requires small volumes of the sample (15-0 µL), and is ideal for testing dilute solutions.
- Ideal for: applications, where measuring the osmolality of aqueous solutions with viscosity close to that of water is required.
- Offers good comparability with results from other laboratories as this measurement method is more commonly used. There is a preference for freezing point depression osmometers in clinical guidelines and standards, as these osmometers provide reliable measurements for solutions commonly encountered in clinical settings.
- Effective in a variety of research applications, particularly when testing complex solutions.
These are the most commonly recommended applications, though its use is not restricted to these areas.
Considerations:
- Insoluble particulates in the tested solution may create nucleation points, leading to premature freezing and less accurate results.
- Not suitable for highly viscous samples. "Delayed" crystallization can cause seemingly elevated readings, often due to high concentrations or increased viscosity of the solution.
- Coagulation and surface effects may lead to uneven solute dispersion within the solution, resulting in readings that are unexpectedly high or low.
- Measuring principle is limited by solutes which inhibit ice crystal formation or induce pre-freezing by nucleating crystal formation.
Vapro® Vapor Osmometer
The advantages of a VPO include the measurement of osmolality in the upper measuring range and a small sample volume (2 to 60 µL, where the Vapro's standard sample size is 10 µL). The measurement time is approximately 120 s/sample.
- Ideal for: research and industrial applications, especially when measuring the osmolality of tissue samples or highly viscous solutions. Additionally beneficial for certain clinical applications that require very small sample volumes or involve highly viscous samples.
- Can test gross samples (e.g., tissues) in addition to solutions.
- Does not alter the physical state of the sample as does freezing point osmometry.
These are the most commonly recommended applications, though its use is not restricted to these areas.
Considerations:
- It should not be used for solutions containing volatile chemicals, as this can produce artificially low or inaccurate results.
- Environmental conditions, such as humidity and pressure, can affect the readings. The device typically requires a controlled environment for optimal performance.
- The thermocouple can be easily contaminated, leading to inaccurate readings. The chemical compatibility of the sensor (thermocouple) must be considered.
Conclusion
Both the FreezePoint and Vapro provide reliable osmolality measurements, although variations may arise due to their differing operating principles. Factors such as non-ideality of solutions, temperature dependence, and device limitations contribute to these discrepancies. Understanding these factors allows professionals in clinical, pharmaceutical, research, and industrial sectors to make informed decisions regarding osmolality measurements, ensuring optimal results for individual applications.
Areas of Application

Peer Reviews from SelectScience®
"Reliable, accurate, and easy-to-use instrument for measuring osmolality."
The FreezePoint® Freezing Point Osmometer is a highly reliable and accurate instrument designed for measuring osmolality in various applications.
It offers easy operation and calibration, requires minimal maintenance, and delivers precise results with a measurement range of 0-2000 mOsm/kg and an accuracy of ± 2 mOsm/kg.
Its speed is also notable, providing results in as little as 60 seconds. Overall, it's an excellent choice for medical, pharmaceutical, and industrial laboratories.
"Beautiful equipment, essentiel for any lab that need to measure precise osmolarity."
Very easy to set up calibrate and use. I had an old Osmomat bought in the years which when I switched it on after more than a decade in storage worked perfectly first time and didn't even need to be recalibrated (which we did anyway but it was perfect). We upgraded last year and bought the osmomat 300 which use the same principle but can be plugged and monitor by a computer and send results on our network. It works perfectly, very reliable and very consistent results. It is sensitive and of course the imprecision increases with the concentration of the solutions but even for multimoles/kg solutions it is under 1%.
I highly recommend this product to anyone who need to check their solutions osmolarity. We work with expensive cell lines, primary cells, plasma samples, extracellular fluids, different medium etc. our results depend on precise osmolarity and it saved us massive headaches and lot of money to be able to set it precisely and to check the osmolarity of the mediums we bought.
"The reliability, accuracy and precision of the unit is what separates it from other units."
I purchased a vapor pressure osmometer back in 2017 when I established a stability lab to test cell culture media, process buffers and buffers both internal and external customers.
The unit has been very reliable, precise, accurate and easy to use.
I have most recently had more than five chemists in my lab using the unit. Its flexibility to interphase with LIMS has greatly improved GMP compliance and the quality of the data we generate.
This product has more potential in our current science spheres and could be enhance with more friendly user interphase.